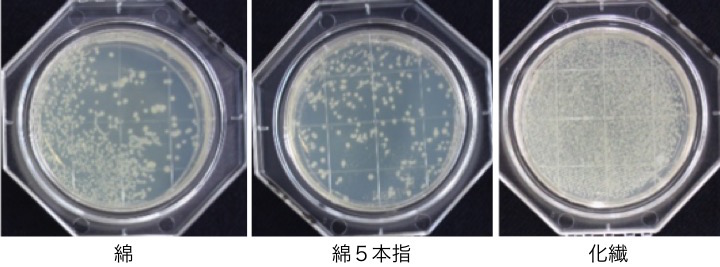

「5本指ソックス」や「足用の制汗デオドラント剤」で足のニオイケア
「自分や他人の足のニオイが気になった経験がある」人は約9割。詳しく調べてみると、自分より他人の足のニオイを気にする人が圧倒的に多いようです。足のニオイには綿素材の5本指ソックスが効果的!綿普通型、化繊、素足に比べ、ニオイ不快度が低いことがわかりました。足用の制汗デオドラント剤なども上手に活用しましょう。
9割近くの人が自分や他人の「足のニオイ」に困った経験がある!
生活の環境が変わる、4月からの新生活。自分の身だしなみを特に気にする時期でもありますよね。皆さんは、「足のニオイ」のケアをきちんとできていますか?
20〜50代の男女に「お座敷や新幹線、車など、靴を脱ぐこともある場で、自分や他人の足のニオイが気になったことはありますか?」という質問をしたところ、9割近くの人が「ある」と答えました。「他人の家に行ってブーツを脱いだ時に、足が臭くて困った」「仕事終わりの自分の足のニオイがとても臭いので、靴下の替えを常に持っている」など、自分の足のニオイに気付き、困った経験や対策をしている人も。しかし、自分より他人のニオイが気になったという意見が圧倒的に多く、「映画館で靴を脱いでいる人のニオイが気になって集中できなかった」「宴会場所がお座敷で隣の人の足のニオイが臭すぎて食欲がなくなった」「友達と車で寝泊りをした時にあまりの臭さで目が覚めた」など、他人の足のニオイは意外と深刻。歓送迎会などでお座敷にあがる機会も増える春、他人に不快感を与えないためにも、しっかり対策しておきたいところです。
<足のニオイに関するアンケート>
お座敷や新幹線・車など、靴を脱ぐこともある場で、自分もしくは人の足のニオイが気になったことはありますか?
どんな靴下を履けば足のニオイはおさえられるの?
素足より、靴下を履いた方が足のニオイが気にならないという検証結果はこちらでご紹介していますが、今回はさらに「靴下の種類」でニオイをおさえる効果は上がるのか検証を行いました。
男性20名に「綿」「綿5本指」「化繊(化学繊維)」と、種類の違う靴下を履いてもらい、脱いだあとの靴下に、ニオイなどの原因となる菌がどれくらいついているか、観察しました。
その結果、「綿5本指」の靴下には菌が少なく、「化繊」の靴下には最も多く菌が見られました。
また、脱いだ靴下の「ニオイ不快度」を評価したところ、「化繊」よりも「綿」の靴下の方が低く、特に「綿5本指」の靴下の「ニオイ不快度」が低いことがわかりました。
最近、巷でよく見かける5本指靴下(綿)には、ニオイ不快度を下げる効果があったのです。とは言え、この「5本指靴下」。「履きたいけど、まわりの視線が気になる」という声もありました。皆さんの「5本指靴下」への意識はどうなっているのでしょうか。
5本指靴下を履いている人ってどれくらい?
「5本指靴下を履いた経験があるか」アンケートを取ってみると、6割の人が履いた経験があると回答。ただし、そのうち「1か月以内に履いたことがある」という回答は全体の2割程度にとどまり、残りの4割は「以前は履いていたが、最近は履いていない」という結果となりました。5本指靴下が一般に浸透し話題になった時期、一度は履いた経験があるものの、何らかの理由により履かなくなってしまったのでしょうか。
<5本指靴下を履いたことがあるかアンケート>
「5本指靴下を履いたことがありますか?(SA)
男性はかっこ悪いと思っている!?女性の方が履いている「5本指靴下」
先ほどのアンケートを男女別に分けてみると、下のグラフのような結果に。「5本指靴下を履いた経験がない」男性は、女性よりも約15%も多いということがわかりました。
<5本指靴下を履いたことがあるかのアンケート>
5本指靴下を履いたことがありますか?
そこで、「5本指靴下を履いたことがない、もしくは現在は履いていない理由」を男女別に聞いてみました。
<5本指靴下を履かない理由>
「5本指靴下」を履いていない、もしくは履いたことがない理由はなんですか?
男女ともに「なんとなく履く機会がなくなった(なかった)」がトップでしたが、「見た目が好みでない」という回答が2位に上がっていました。その割合は、男性は女性の約1.4倍となり、男性の場合は「5本指靴下を履いているとかっこ悪い」という意識が高いようです。
「5本指靴下がかっこ悪い」という印象は男女でギャップあり!
では、女性は「5本指靴下」を履いている男性について、実際はどう思っているのでしょうか。女性に「5本指靴下を履いている男性に対して、どういう印象を受けますか?」という質問をしたところ、3割程度が「健康的、健康意識が高い」、2割弱が「何も思わない」と回答し、「見た目がかっこ悪い」と答えたのはわずか1割程度となりました。男性自身の意識と、女性が見ている印象にはギャップがあるようです。
<5本指靴下を履いている男性への印象>
「5本指靴下」を履いている男性からどういう印象を受けますか?(SA女性)
靴下か制汗デオドラント剤で足のニオイケア
足のニオイは靴下の素材を「綿」、特に「5本指靴下」であるとおさえられることがわかりました。さらに、5本指靴下への意識調査によると「5本指靴下を履いている異性」に対する印象は男女間にギャップがあり、男性にとっては「かっこ悪い」と感じる5本指靴下ですが、女性にとってはさほど気にならないようですから、ぜひ上手に利用してみてください。見た目を気にして足が臭ってしまっては、本末転倒ですよね。フォーマルな場や、どうしても見た目を気にして履けない時には、足用の制汗デオドラント剤などを使って足のエチケットケアをする方法もおすすめします。
この記事を作成・監修した
マイスター

衛生マイスター
浅野 ほたか
あさの ほたか
界面活性剤の基礎研究14年、身体洗浄・消毒(手、身体、毛髪)や台所用洗剤、調理分野の製品開発17年と、およそ30年間研究に携わってきました。
これまでの経験を活かし、生活における様々なシーンでの衛生に関わる情報をわかりやすく発信していきます。
健康・美容の新着記事もチェック!
LION おすすめの商品
※ ここから先は外部サイトへ移動します。価格やサービス内容については、各サイトに記載されている内容をよくお読みになり、ご自身の責任でご利用ください。
※ 通販限定販売品は、「取扱店舗を探す」ではご案内しておりませんのでご了承ください。

下記のコメントを削除します。
よろしいですか?
コメント内容コメント内容コメント内容コメント内容コメント内容コメント内容コメント内容コメント内容コメント内容コメント内容コメント内容コメント内容コメント内容コメント内容コメント内容コメント内容コメント内容コメント内容コメント内容コメント内容コメント内容コメント内容コメント内容コメント内容コメント内容コメント内容コメント内容コメント内容コメント内容コメント内容コメント内容コメント内容コメント内容コメント内容コメント内容コメント内容